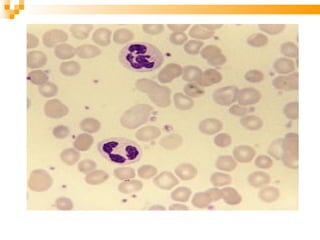
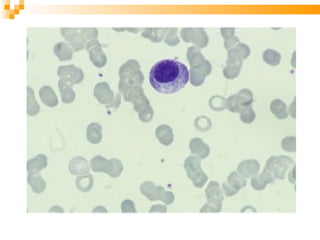

El documento habla sobre la anemia hemolítica autoinmune (AHAI), una enfermedad caracterizada por la destrucción prematura de eritrocitos mediada por autoanticuerpos. Estos autoanticuerpos pueden ser de clase IgG "calientes" o IgM "fríos". La AHAI puede deberse a medicamentos, y sus síntomas incluyen debilidad, mareos, fiebre y orina oscura. El tratamiento incluye transfusiones, corticoides e inmunosupresores.